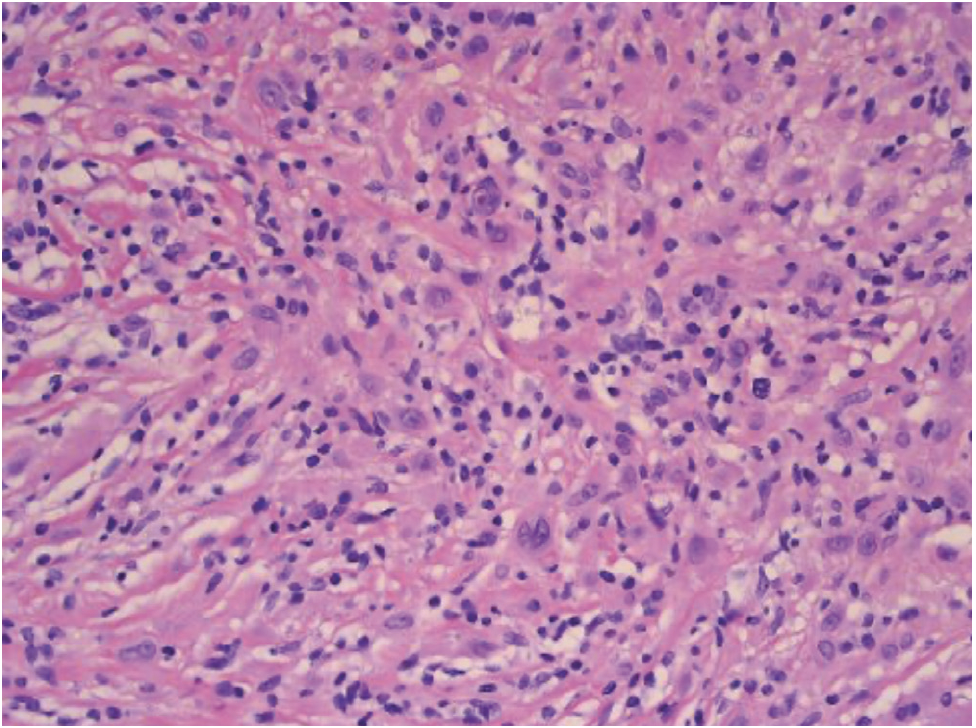
Figure5

What Is This Red-Brown Lesion on the Patient’s Back?
© 2023 HMP Global. All Rights Reserved.
Any views and opinions expressed are those of the author(s) and/or participants and do not necessarily reflect the views, policy, or position of The Dermatologist or HMP Global, their employees, and affiliates.
Case Report

Case Report
A 35-year-old man with no personal or family history of skin cancer was referred to the dermatology clinic by his primary care provider due to a suspicious lesion on the back identified 2 months ago via teledermatology imaging. The lesion was raised, red-brown, and located on the mid upper back. The patient reported that it had been developing for a year, was itchy, and was changing in size.
Teleimaging revealed an irregular brown and pink papule on the mid upper back (Figure 1). Due to the number of nevi on the image and the irregularity of the mid upper back lesion, an in-person total body skin evaluation was recommended. Physical examination confirmed actinic changes; scattered regular brown macules on the trunk and extremities; and a 4-mm light brown, soft, compressible papule on the mid upper back (Figure 2). A shave biopsy was performed.
What Is The Diagnosis?
Check your answer below.
Diagnosis
BAP1-inactivated melanocytic tumor
BAP1-inactivated melanocytic tumors (BIMTs) can present with various morphology, from pink nodules or flesh-colored papules to color variegated pink and tan papules. The varied clinical presentations necessitate biopsy for diagnosis (eTable).1-3 BIMTs are considered benign; however, malignant transformation is possible. Complete surgical removal is therefore recommended and was performed in our patient. A genetic consultation was ordered to evaluate for a BAP1-associated cancer susceptibility syndrome. BAP1 tumor predisposition syndrome (BAP1-TPDS) is an autosomal dominant disease in which germline mutations in BAP1, a tumor suppressor gene, lead to a genetic predisposition toward developing cancer. The associated neoplasms in this syndrome include early-onset renal cell carcinoma, mesothelioma, uveal and cutaneous melanoma, and several other carcinomas.4 Therefore, genetic testing is recommended when BIMT is encountered.2,5,6

Histology
Pathology revealed a conventional appearing, compound melanocytic proliferation with central nodular expansion by a predominantly dermal epithelioid melanocytic proliferation exhibiting prominent nuclear pleomorphism, including bizarre appearing cells with prominent nucleoli and abundant pale cytoplasm. No mitoses were identified within the conventional or central atypical dermal components. The atypical epithelioid melanocytes intercalated through sclerotic collagen with scattered, evenly admixed lymphocytes. Occasional nests of junctional melanocytes were located at the tips of rete ridges with no bridging, upward migration, or confluence of melanocytes.
Sox10, Melan-A, HMB-45, and Ki-67 immunohistochemical stains were initially utilized in the evaluation of this case. Sox10 and Melan-A stains highlighted both the conventional appearing and atypical melanocytes. HMB-45 stain was negative in the atypical epithelioid population and showed dermal gradient staining within the conventional dermal nevus component. Ki-67 staining revealed a low proliferative index in all melanocytes. Additional immunohistochemical staining for BAP1 showed retained nuclear staining within the conventional nevus with a lack of nuclear staining of the atypical epithelioid population, confirming the diagnosis of a BIMT (Figures 3–6).

Our Patient
After complete surgical removal of the patient’s BIMT, a genetic consultation determined that his family history did not warrant further genetic testing. The patient was advised to come in for regular 6-month skin examinations and ophthalmologic evaluation to monitor for the development of additional BIMTs and other melanocytic neoplasms. Although BIMTs generally have an indolent clinical course, there is still concern for malignant transformation. Thus, cancer surveillance should be performed on all patients presenting with BIMTs.1,9

Conclusion
BIMTs have variable clinical and histopathologic presentations. This report serves to highlight the need for referring these patients to genetic testing and subsequent appropriate cancer screenings given the association with BAP1-TPDS.
References
1. Zhang AJ, Rush PS, Tsao H, Duncan LM. BRCA1-associated protein (BAP1)-inactivated melanocytic tumors. J Cutan Pathol. 2019 Dec;46(12):965-972. doi:10.1111/ cup.13530
2. Wiesner T, Obenauf AC, Murali R, et al. Germline mutations in BAP1 predispose to melanocytic tumors. Nat Genet. 2011;43(10):1018-1021. doi:10.1038/ng.910
3. Soares de Sá BC, de Macedo MP, Torrezan GT, et al. BAP1 tumor predisposition syndrome case report: pathological and clinical aspects of BAP1-inactivated melanocytic tumors (BIMTs), including dermoscopy and confocal microscopy. BMC Cancer. 2019;19(1):1077. doi:10.1186/s12885-019-6226-8
4. Rai K, Pilarski R, Cebulla CM, Abdel-Rahman MH. Comprehensive review of BAP1 tumor predisposition syndrome with report of two new cases. Clin Genet. 2016;89(3):285-294. doi:10.1111/cge.12630
5. Pilarski R, Carlo MI, Cebulla C, Abdel-Rahman M. BAP1 tumor predisposition syndrome. In: Adam MP, Ardinger HH, Pagon RA, et al, eds. GeneReviews. October 13, 2016. Updated March 24, 2022. https://www.ncbi.nlm.nih.gov/books/ NBK390611
6. Carbone M, Ferris LK, Baumann F, et al. BAP1 cancer syndrome: malignant mesothelioma, uveal and cutaneous melanoma, and MBAITs. J Transl Med. 2012;10:179. doi:10.1186/1479-5876-10-179
7. Yélamos O, Navarrete-Dechent C, Marchetti MA, et al. Clinical and dermoscopic features of cutaneous BAP1-inactivated melanocytic tumors: results of a multicenter case-control study by the International Dermoscopy Society. J Am Acad Dermatol. 2019;80(6):1585-1593. doi:10.1016/j.jaad.2018.09.014
8. Fischer, AS, High, WA. The difficulty in interpreting gene expression profiling in BAP-negative melanocytic tumors. J Cutan Pathol. 2018;45:659-666. doi:10.1111/ cup.13277
9. Zaayman M, Nguyen P, Silfvast-Kaiser A, et al. BAPoma presenting as an inciden tal scalp papule: case report, literature review, and screening recommendations for BAP1 tumor predisposition syndrome. J Dermatolog Treat. 2022;33(4):1855- 1860. doi:10.1080/09546634.2021.1939847


















